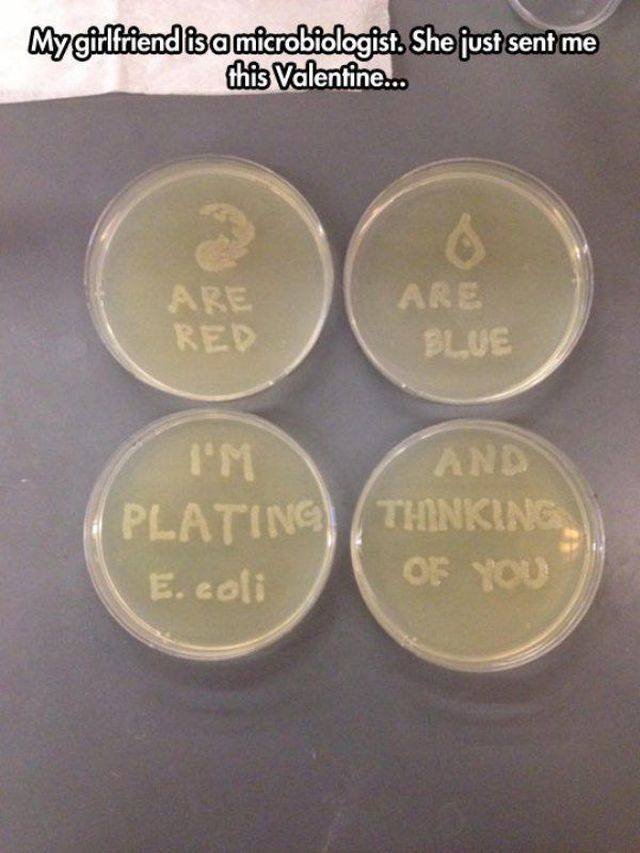
Daily Picdump

We care about our visitors and respect personal information which you share with us. It is important to us that you are aware of data we are collecting about you and how we are doing it. Due to this we are updating our Privacy Policy and Cookie Policy. These updates will come into effect starting from May 25, 2018.
By using the site zenbokap.pages.dev after May 25, 2018 you are acknowledging that you agree with the changes made in Privacy Policy, which you can read in detail here
Tags
awesome, bonus pictures, boobs, curiosities, cute, Daily picdump, demotivational, dirty, drunk, Facts, fail, fails, funny, Funny picdump, funny pictures, gifs, girl, girls, grownup corner, hilarious, hot, hot girls, humor, interesting, lol, look, memes, nsfw, people, pictures, sex, sexy, sexy girls, some, stuff, these, weird, win, women, wtf
Archives
- October 2024 (92 entries)
- September 2024 (111 entries)
- August 2024 (135 entries)
- July 2024 (133 entries)
- June 2024 (140 entries)
- May 2024 (155 entries)
- April 2024 (145 entries)
- March 2024 (146 entries)
- February 2024 (143 entries)
- January 2024 (148 entries)
- December 2023 (144 entries)
- November 2023 (151 entries)
- October 2023 (154 entries)
- September 2023 (150 entries)
- August 2023 (159 entries)
- July 2023 (152 entries)
- June 2023 (152 entries)
- May 2023 (159 entries)
- April 2023 (146 entries)
- March 2023 (158 entries)
- February 2023 (142 entries)
- January 2023 (139 entries)
- December 2022 (144 entries)
- November 2022 (151 entries)
- October 2022 (149 entries)
- September 2022 (151 entries)
- August 2022 (161 entries)
- July 2022 (149 entries)
- June 2022 (131 entries)
- May 2022 (130 entries)
- April 2022 (131 entries)
- March 2022 (131 entries)
- February 2022 (118 entries)
- January 2022 (130 entries)
- December 2021 (127 entries)
- November 2021 (133 entries)
- October 2021 (126 entries)
- September 2021 (127 entries)
- August 2021 (114 entries)
- July 2021 (125 entries)
- June 2021 (126 entries)
- May 2021 (128 entries)
- April 2021 (131 entries)
- March 2021 (136 entries)
- February 2021 (131 entries)
- January 2021 (138 entries)
- December 2020 (140 entries)
- November 2020 (145 entries)
- October 2020 (155 entries)
- September 2020 (148 entries)
- August 2020 (154 entries)
- July 2020 (187 entries)
- June 2020 (163 entries)
- May 2020 (106 entries)
- April 2020 (77 entries)
- March 2020 (72 entries)
- February 2020 (77 entries)
- January 2020 (72 entries)
- December 2019 (72 entries)
- November 2019 (60 entries)
- October 2019 (96 entries)
- September 2019 (126 entries)
- August 2019 (117 entries)
- July 2019 (30 entries)
- June 2019 (52 entries)
- May 2019 (93 entries)
- April 2019 (83 entries)
- March 2019 (84 entries)
- February 2019 (76 entries)
- January 2019 (143 entries)
- December 2018 (143 entries)
- November 2018 (147 entries)
- October 2018 (161 entries)
- September 2018 (151 entries)
- August 2018 (151 entries)
- July 2018 (154 entries)
- June 2018 (148 entries)
- May 2018 (147 entries)
- April 2018 (146 entries)
- March 2018 (140 entries)
- February 2018 (131 entries)
- January 2018 (129 entries)
- December 2017 (130 entries)
- November 2017 (150 entries)
- October 2017 (159 entries)
- September 2017 (147 entries)
- August 2017 (164 entries)
- July 2017 (144 entries)
- June 2017 (149 entries)
- May 2017 (129 entries)
- April 2017 (123 entries)
- March 2017 (150 entries)
- February 2017 (138 entries)
- January 2017 (115 entries)
- December 2016 (137 entries)
- November 2016 (145 entries)
- October 2016 (152 entries)
- September 2016 (125 entries)
- August 2016 (147 entries)
- July 2016 (103 entries)
- June 2016 (123 entries)
- May 2016 (130 entries)
- April 2016 (107 entries)
- March 2016 (121 entries)
- February 2016 (91 entries)
- January 2016 (98 entries)
- December 2015 (114 entries)
- November 2015 (112 entries)
- October 2015 (113 entries)
- September 2015 (113 entries)
- August 2015 (79 entries)
- July 2015 (116 entries)
- June 2015 (108 entries)
- May 2015 (106 entries)
- April 2015 (113 entries)
- March 2015 (113 entries)
- February 2015 (109 entries)
- January 2015 (108 entries)
- December 2014 (105 entries)
- November 2014 (97 entries)
- October 2014 (147 entries)
- September 2014 (126 entries)
- August 2014 (136 entries)
- July 2014 (112 entries)
- June 2014 (126 entries)
- May 2014 (132 entries)
- April 2014 (137 entries)
- March 2014 (121 entries)
- February 2014 (117 entries)
- January 2014 (96 entries)
- December 2013 (27 entries)
- November 2013 (32 entries)
- October 2013 (26 entries)
- September 2013 (34 entries)
- August 2013 (30 entries)
- July 2013 (66 entries)
- June 2013 (67 entries)
- May 2013 (66 entries)
- April 2013 (74 entries)
- March 2013 (86 entries)
- February 2013 (84 entries)
- January 2013 (90 entries)
- December 2012 (86 entries)
- November 2012 (103 entries)
- October 2012 (108 entries)
- September 2012 (82 entries)
- August 2012 (84 entries)
- July 2012 (80 entries)
- June 2012 (60 entries)
- May 2012 (57 entries)
- April 2012 (58 entries)
- March 2012 (67 entries)
- February 2012 (57 entries)
- January 2012 (50 entries)
- December 2011 (39 entries)
- November 2011 (52 entries)
- October 2011 (52 entries)
- September 2011 (57 entries)
- August 2011 (54 entries)
- July 2011 (28 entries)
- June 2011 (27 entries)
- May 2011 (17 entries)
- April 2011 (25 entries)
- March 2011 (19 entries)
- February 2011 (17 entries)
- January 2011 (15 entries)
- December 2010 (12 entries)
- November 2010 (22 entries)
- October 2010 (20 entries)
- September 2010 (16 entries)
- August 2010 (21 entries)
- July 2010 (23 entries)
- June 2010 (51 entries)
- May 2010 (55 entries)
- April 2010 (26 entries)
- March 2010 (49 entries)
- February 2010 (69 entries)
- January 2010 (49 entries)
- December 2009 (82 entries)
- November 2009 (97 entries)
- October 2009 (111 entries)
- September 2009 (116 entries)
- August 2009 (106 entries)
- July 2009 (114 entries)
- June 2009 (85 entries)
- May 2009 (86 entries)
- April 2009 (112 entries)
- March 2009 (85 entries)
- February 2009 (68 entries)
- January 2009 (89 entries)
- December 2008 (5 entries)